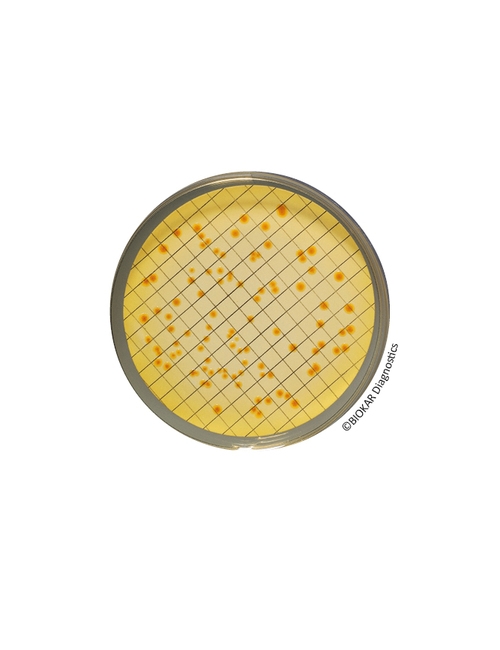
img

Tergitol 7 Agar
Tergitol 7 Agar
Tergitol 7 Agar, membran filtrasyon yöntemiyle, içme suyu başta olmak üzere Escherichia coli ve koliform bakterilerinin sayımı için kullanılır. Bu besiyeri ayrıca yüzme havuzu suyunu test etmek için kullanılır.

Ürün Adı: Tergitol 7 Agar Selective supplement
Ürün Kodu: BS02608
Miktar: 10 şişe x 500 mL

Ürün Adı: Tergitol 7 Agar
Ürün Kodu: BK123HA
Miktar: 500 g

Ürün Adı: Tergitol 7 Agar
Ürün Kodu: BM09308
Miktar: 120 Petri plates Ø 55 mm
Ürün Adı: Tergitol 7 Agar
Ürün Kodu: BM14708
Miktar: 20 Petri plates Ø 55 mm
